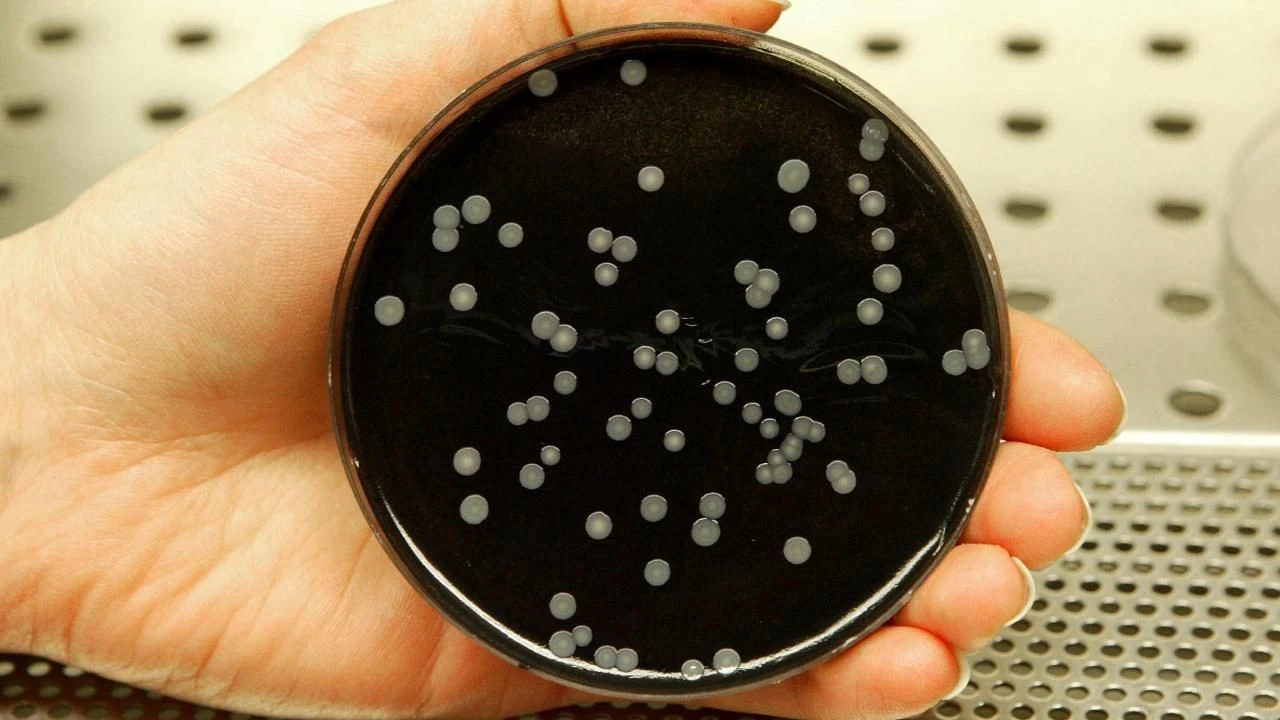
Lejyonella 3 kişiyi öldürdü, giderek yayılıyor! Özellikle tatilciler dikkat! - 2. Resim

Kategoriler
UYGULAMALAR
İstanbul

İtalya'nın Milano şehrinde ortaya çıkan salgın sırasında 3 hasta Lejyoner hastalığı nedeniyle hayatını kaybetti. Havuzlardan, klimalardan bulaşabilen lejyonella bakterisine yakalananlarda yüksek oradan herhangi bir belirti görülmüyor. Fakat hastalanan kişilerin bazıları, zatürreye yol açabilen hastalığa yakalanıyorlar.
Avrupa Hastalık Önleme ve Kontrol Merkezi'nin (ECDC) verilerine göre, Lombardiya bölgesinde en az 49 vaka var. Hastaların yaşı 26 ila 94 arasında ve 28'i kadın, 21'i ise erkek. Ayrıca hastaların çoğunluğunda altta yatan bir sağlık sorunu var.

Dünya Sağlık Örgütü'ne (WHO) göre, en yaygın bulaşma şekli kirli su kaynaklarından çıkan enfekte su spreyleri.
Yetkililer, daha fazla vakanın ortaya çıkmasını önlemek amacıyla bölgedeki soğutma kulelerini denetliyor ve su sistemlerini klorla temizliyor.
Lejyonella bakterileri birkaç gün boyunca kullanılmayan duş ve musluklarda barınabiliyor. Bu nedenle bazı uzmanlar tatilcilere, musluk ve duşları kullanmadan önce muslukları ve duşları açmaları konusunda uyarıda bulunuyor.
Ölümlere neden olan Lejyoner hastalığının belirtileri arasında ise öksürük, nefes almada zorluk, göğüs ağrısı, ateş, grip benzeri semptomlar var.